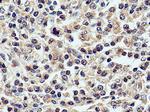
CXCL8/IL8 Antibody in Immunohistochemistry (Paraffin) (IHC (P))

Search
Proteintech
CXCL8/IL8 Polyclonal Antibody
{{$productOrderCtrl.translations['antibody.pdp.commerceCard.promotion.promotions']}}
{{$productOrderCtrl.translations['antibody.pdp.commerceCard.promotion.viewpromo']}}
{{$productOrderCtrl.translations['antibody.pdp.commerceCard.promotion.promocode']}}: {{promo.promoCode}} {{promo.promoTitle}} {{promo.promoDescription}}. {{$productOrderCtrl.translations['antibody.pdp.commerceCard.promotion.learnmore']}}
产品信息
27095-1-AP
种属反应
已发表种属
宿主/亚型
分类
类型
抗原
偶联物
形式
浓度
规格
纯化类型
保存液
内含物
保存条件
运输条件
产品详细信息
Immunogen sequence: YSKPFHPKF IKELRVIESG PHCANTEIIV KLSDGRELCL DPKENWVQRV VEKFLKRAEN S (40-99 aa encoded by BC013615)
靶标信息
Interleukin 8 (IL-8, CXCL8) is a 72 amino acid pro-inflammatory factor which belongs to the CXC subfamily of chemokines, and are bound by the cell surface receptors IL-8RA and IL-8RB. IL-8 functions as a chemoattractant and potent angiogenic factor. The expression and secretion of IL-8 can be induced by diverse inflammatory stimuli in many cells, including macrophages and endothelial cells. In endothelial cells, IL-8 is present in storage vesicles called Weibel-Palade bodies. IL-8, first isolated from osteosarcoma cells, contains the ELR-motif (N-terminal Glu-Leu-Arg amino acid sequence) and signals through the CXCR1 and CXCR2 receptors. Previous nomenclature for IL-8 includes neutrophil activating protein 1 (NAP-1), granulocyte chemotactic protein 1 (GCP-1), monocyte-derived neutrophil-activating peptide (MONAP) and protein 3-10C. IL-8 and ten other members of the CXC chemokine gene family form a chemokine gene cluster in a region mapped to chromosome 4q. Cancer studies have demonstrated a role for IL-8 in the angiogenesis and growth of tumours, and IL-8 is believed to play a role in the pathogenesis of bronchiolitis, a common respiratory tract disease caused by viral infection.
仅用于科研。不用于诊断过程。未经明确授权不得转售。
生物信息学
蛋白别名: alveolar macrophage chemotactic factor I; ANX7; beta endothelial cell-derived neutrophil activating peptide; beta-thromboglobulin-like protein; beta-thromboglobulin-like protein precursor; C-X-C motif chemokine 8; Chemokine (C-X-C motif) ligand 8; Emoctakin; GCP-1; Granulocyte chemotactic protein 1; IL-8; IL8; ILN; Interleukin; interleukin 8; Interleukin-8; Interleukin8; lung giant cell carcinoma-derived chemotactic protein; lymphocyte derived neutrophil activating peptide; MDNCF; MONAP; Monocyte-derived neutrophil chemotactic factor; Monocyte-derived neutrophil-activating peptide; monocyte-derived neutrophil-activating protein precursor; NAP-1; neutrophil-activating peptide 1; Neutrophil-activating protein 1; Protein 3-10C; RP11-537A6.8; small inducible cytokine subfamily B, member 8; SNX; SYNEXIN; T-cell chemotactic factor; tumor necrosis factor-induced gene 1; unnamed protein product
基因别名: CXCL8; GCP-1; GCP1; IL8; LECT; LUCT; LYNAP; MDNCF; MONAP; NAF; NAP-1; NAP1; SCYB8
UniProt ID: (Human) P10145
Entrez Gene ID: (Human) 3576